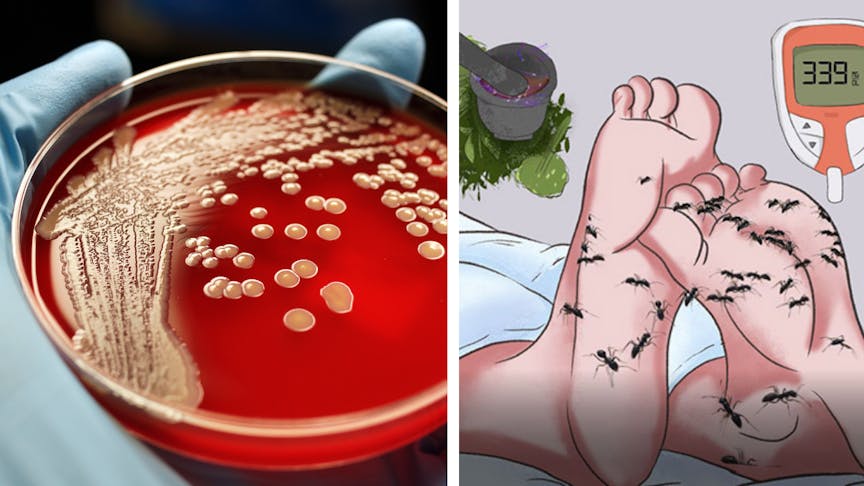
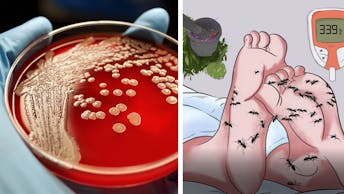

Top Doctor: Do This 10-Second Technique Tonight To Regain Perfect Blood Sugar Levels

Make sure your sound is turned on. Please wait up to 10 seconds for the video to load.
Dr. Kumar, a leading medical professor and endocrinologist, has just blown the whistle on a breakthrough type-2 reversing technique.
He exposes the true cause of uncontrollable blood sugar, and it has nothing to do with carbohydrates, sugar intake or family history, but is actually due to a shortage of unique cells that line the pancreas.
A clinically proven, 10-second evening technique has been released that unleashes the body's ability to replenish these cells, naturally balancing sugar levels overnight, without traditional treatments that only keep the symptoms at bay.
Over 44,200 men and women are already using this evening technique to balance sugar as they sleep. Eliminating the risk of the debilitating problems linked to type-2 diabetes, all without restrictive diets, difficult exercise, and absolutely no pills or capsules.
Most people continue to suffer medication side effects because they've been brainwashed by the medical industry to believe type 2 is a hereditary condition...
Watch this eye-opening video now before big pharma succeeds in getting it taken down. Tap the button above or below.
Be Strong!
Discover how thousands of people don't have to worry anymore about blood sugar spikes, finger pricks, strokes or amputations.
© 2023 PositivVibe
Privacy Policy | Terms of Service | Earnings | DMCA | Contact Us | Home
This site is not a part of the Youtube website or Youtube Inc. Additionally, this site is NOT endorsed by Youtube in any way.
YOUTUBE is a trademark of Youtube, Inc.
Disclaimer: All information provided is for educational use only. Proper due diligence is always recommended before starting any type of programs. positivvibe.com contains general information about medical treatments. The information is not advice and should not be treated as such.
No warranties: The medical information provided on positivvibe.com is provided without any representations or warranties, express or implied.
Professional assistance: Do not rely on the information on positivvibe.com as an alternative to medical advice from your doctor or other professional healthcare providers. If any questions arise about your current health situation go ahead and consult your doctor. Never delay seeking medical advice, disregard medical advice, or discontinue medical treatment because of information on my positivvibe.com
Limiting our liability: The visitors of this website not to hold us liable for any damages arising from or relating to your reliance on any of the medical information provided on positivvibe.com. Additionally, the visitors agree not to repeat the medical information on this site to a third party, friends, family, etc, as that person may not have read this disclaimer and understood the caveats involved in receiving this information
A PositivVibe